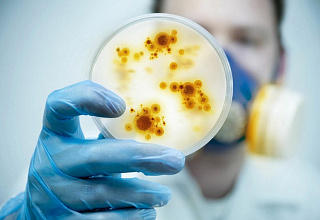
alt

- Объективно
- Спорт
- 80 добрых дел. Новогрудок помнит
- 80 лет Великой Победы
- 80 лет Гродненской области
- 85 лет Новогрудскому району
- Беларусь - это мы
- Благоустройство и порядок
- Боль и память
- Год благоустройства
- Города побратимы
- Гороскоп
- Диалоговая площадка
- ЗОЖ. Здоровье
- Информационный дневник
- Калейдоскоп
- Конституция
- Мнения. Комментарии.
- Молодежь. Будущее. Беларусь.
- Навстречу выборам
-
Наши проекты
- Аб чым маўчаць абеліскі
- Ваша Победа - моя жизнь
- Вуліца імя героя
- Да 80- годдзя вызвалення Навагрудка
- Дорогами сожженных деревень
- З попелам у сэрцы
- История читателя
- Киберпреступность: обман виртуальный – последствия реальные
- Насустрач Перамозе
- Паміж вайной і дзяцінствам
- Памяць пакаленняў: дзеці вайны
- Перамога ў кожным радку
- Республиканский ракурс – позиция своя
- РОСТки будущего
- Новогрудчина на пути к 980-летию
- Новости Новогрудчины
- Нужна помощь
- Отвечает участковый инспектор
- Погода
- Подписка
- Происшествия
- Профилактика. Безопасность
- Сбор предложений по проблемным вопросам законодательства
- Сведкi эпохi
- Содействие занятости
- СТОП Экстремизм
- Туристам на заметку